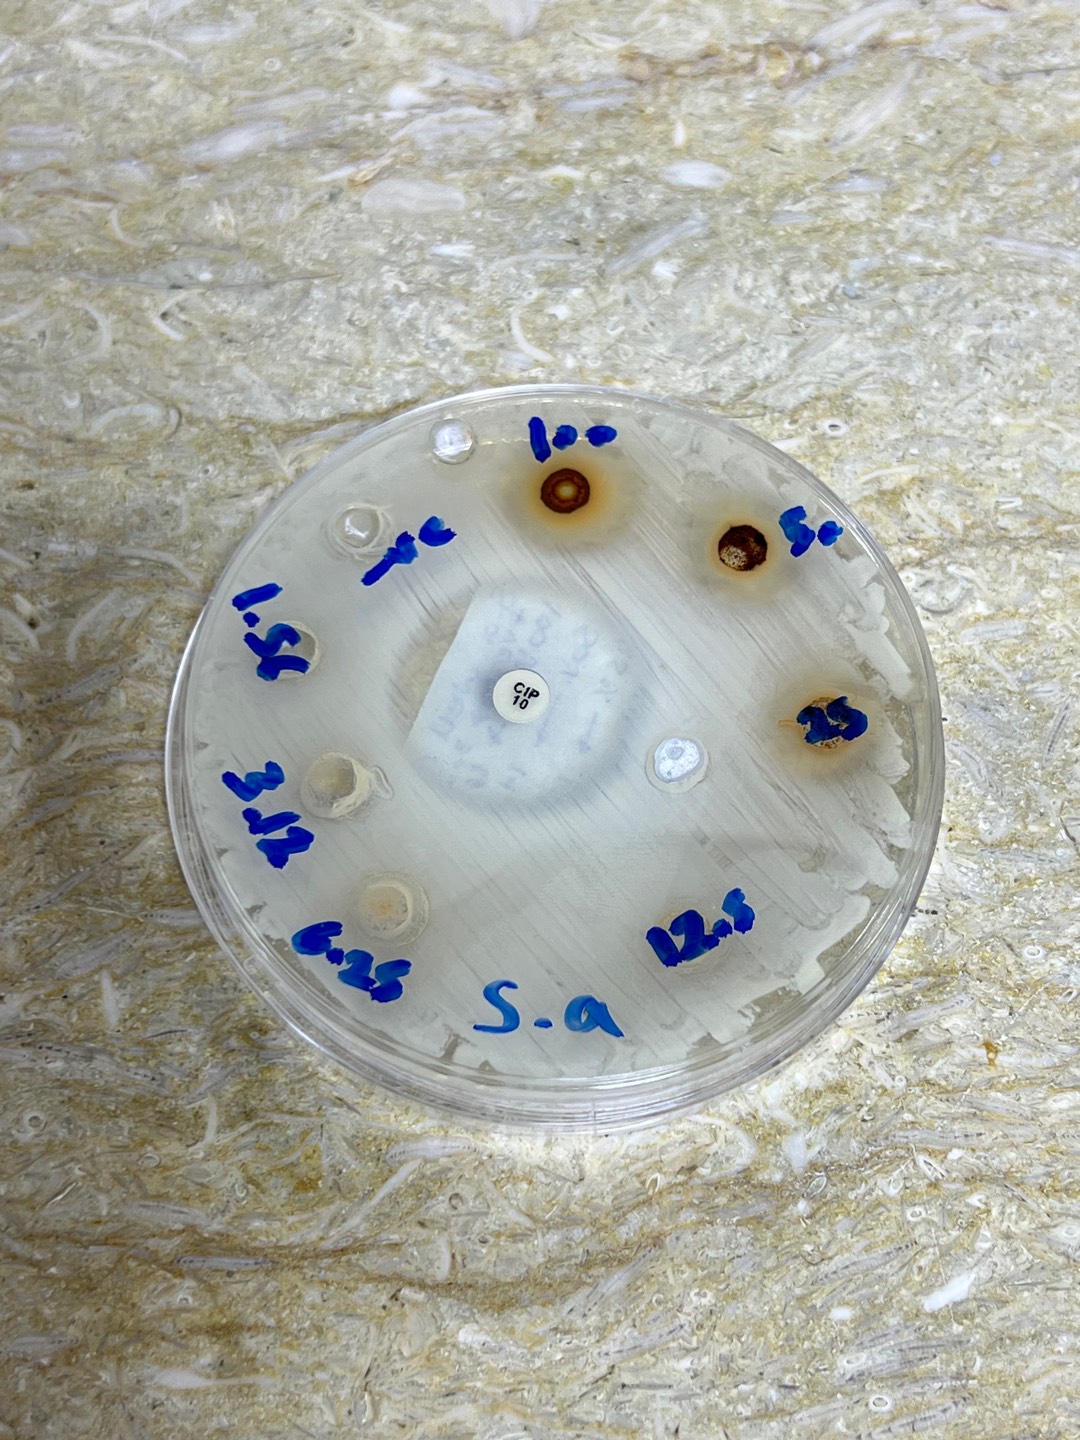

Drag/paste images to upload

Metadata
Tags: -
Image URL
https://fast.image.delivery/lmbuobi.jpgDimensions
1080 × 1440 (0.42 MB)
Uploaded on
2/25/2026, 4:04:17 PM
Drag/paste images to upload
Tags: -
1080 × 1440 (0.42 MB)
2/25/2026, 4:04:17 PM